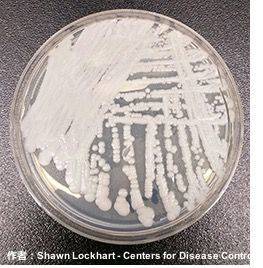
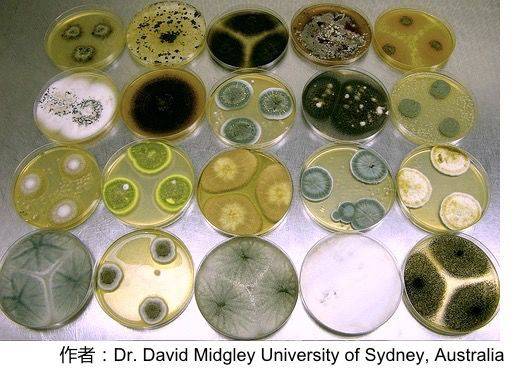

细菌的抗药性是大家都非常熟悉的话题。部分小学生都知道,致病细菌中的一些“刺儿头”可能由于发生突变而产生对抗生素的抵抗能力。也正是基于这种“全民都知道一点名词,但是没有几个人确实完全了解真相”的现状,民众一提到抗生素马上就想到“滥用”和“耐药性”,使用抗生素的时候也小心翼翼,已然成为惊弓之鸟。
然而,细菌抗药性的话题到目前还没被掰扯清楚,耐药真菌又隆重登场了。2019年4月6日,美国《纽约时报》以“致命真菌,治疗无解”为引子报道了一种名为“耳念珠菌”的真菌。这种真菌短短10年时间内在世界各地相继现身,并且仍然在不断开疆拓土。感染者约有半数在90天内死亡,最终死亡率达到60%,且目前仍无特效药物,甚至全世界最顶级的医疗机构都无能为力。
那么,这种可怕的神秘真菌是何时开始现身的?促成它们在世界各地同时出现的诱因又是什么?这次的锅又是抗生素来背?如此高的死亡率会不会造成如中世纪黑死病一般的严重灾难?谜团背后,除却感叹渺小生物亦有的顽强求生本能,人类与环境和其它生物间复杂而微妙的相互作用着实叫人细思极恐。
真菌?细菌?病毒?
在耐药真菌的故事开始之前,我们有必要重新复习一下初中生物课上学习过的这三种微生物。
首先,从结构上来说,病毒最简单,细菌次之,真菌比细菌还要更复杂。如果把病毒比作人力平板车的话,那细菌起码是电三轮,真菌可能就得是小汽车了。
其次,三者都可能导致人类患上疾病,并且治疗时需要采取不同的方式。大部分抗生素都只针对细菌感染,病毒性疾病需要用抗病毒药物来治疗,而真菌感染也有相对应的抗真菌药物。
例如,由于病毒结构简单,不存在细胞壁也不自行合成蛋白质,那么以攻击细胞壁或者阻碍蛋白质合成为抗菌手段的抗生素就无法对病毒发生作用。此外,不是所有抗生素都能够针对各种细菌,如绿脓杆菌,它的细胞壁上开孔较小,很多抗生素无法侵入其内部,因而对其杀灭效果有限。
最后,虽然三者中都有危害人类健康的“大敌”,但也有人类生活不可或缺的盟友。多种真菌在酿造和发酵工业中不可或缺,很多细菌对人类消化和生物圈的物质循环有重要作用,病毒中也有噬菌体可以协助人类杀灭细菌或者帮助人类进行蛋白质合成等等。
肆虐全球的超级真菌:耳念珠菌
接下来,让我们揭开耐药真菌“耳念珠菌”的真容。
耳念珠菌可引起侵袭性念珠菌病,如念珠菌菌血症、心包炎、泌尿道感染和肺炎等。由于其多重耐药性、致死性高、感染诊断困难的特性,它也被称为“超级真菌”。目前,美国疾病控制与预防中心已将耳念珠菌列入“紧急威胁”名单。
2005年,日本组织科研力量对境内的真菌群落进行了一次集中的普查。当时,东京都健康长寿医疗中心的医护人员从一名70岁的日本妇女耳道中采集到了某个样品。在之后持续多年的分析鉴定过程中,科学家们发现这件样品无法归类于现存的任何一种真菌。
于是,日本科学家于2009年首次报道了这种被命名为“耳念珠菌”的新真菌。不料在那之后,亚洲和欧洲多国都爆发了耳念珠菌感染引发的重症案例。
培养皿中的耳念珠菌
美国的第一例病例出现在2013年,当时纽约一处医院救治了一名自诉呼吸不全症状的女性。这位出生于阿联酋的61岁妇女在入院一周后检出耳念珠菌阳性,并最终在不久后去世。不过,鉴于当时耳念珠菌还没有目前这么大的影响力,该医院并未将情况上报,直到2016年美国疾病预防控制中心才接到了来自院方的病例报告。
真正让耳念珠菌开始进入大众视野的是,于2016年在英国皇家布朗普顿医院集中爆发的感染事件。当时,该院一时间出现了72名感染病例,ICU也因此关闭了长达两周之久。由于院方初期对情况严重程度的估计不足,没有在第一时间对社会公开院内情况。
然而,据事后披露的情况显示,早在媒体大规模介入报道之前的数个月,该院已经在内部发出过相关警报,并尝试对疫情出现的区域进行除菌操作。作业人员用专用的气雾剂向收治过感染该真菌患者的区域附近喷洒过氧化氢溶液,理论上这种喷剂的蒸汽会浸透到房间的每个角落。
这些房间维持过氧化氢气雾的饱和状态达一周之久,之后研究人员在房间中央放置一个表面皿,并观察其底部培养基内微生物的生长情况。令人感到恐怖的是,即便如此,仍然有一个耳念珠菌群落在培养皿中现身。然而,这一事件最终被病院隐瞒了下来……
仅仅在过去五年间,耳念珠菌就在美国、西班牙、委内瑞拉、印度、巴基斯坦、南非乃至中国等地的医院中出现,而其中尤以西班牙巴伦西亚大学医院发生的大型感染事件最为惨烈。这所拥有992张病床的大型医院在当时总共出现了372名感染病例,其中85人发生念珠菌菌血症,41%的人在30天内死亡。
多地几乎同时爆发:耐药真菌的神秘起源
耳念珠菌从2009年被发现以来,短短十年间已经在全球多地造成多次杀伤。但真正令研究人员感到费解的是,该种真菌的神秘起源及其在全球的传播路径。
鉴于最早的病例报告于亚洲,最初科学家们推测亚洲出现的毒株引发了全球其它地区的疫情。然而,对采集自南亚、委内瑞拉、南非和日本的毒株进行遗传信息比对后,研究人员们惊奇地发现它们属于四个独立的分支,彼此之间不存在亲缘关系。
进一步的基因序列对比结果显示,这四个分支大约在数千年前从同一个祖先处分离出来,并在世界各地的环境中以无害菌落的形式存在着,直到大约十年前开始同时出现耐药性菌株。也就是说,流行于全球各地的耳念珠菌其实是在几乎一瞬间内同时出现在不同地方,几种菌株分别在各地独立演化,且它们之间平行传播的可能性很小。
到底是什么原因让它们像约好了一样,一起冒出来为祸人间呢?
耳念珠菌病例出现地区分布图
遗憾的是,确切的原因目前仍然不得而知。研究人员最初以耐药细菌产生的原因作为参考,自然地认为抗真菌药剂在临床治疗上的过量使用,是造成真菌出现耐药性的主要原因。但是,临床上治疗真菌感染的药剂种类虽然不多,但致命性的真菌感染其实发病率很低,且抗真菌药的应用场景和抗药性问题暂时也不如细菌普遍。
那么,如果这锅不让滥用抗真菌药来背?到底又是什么因素造成耳念珠菌的突然爆发呢?确切答案虽然还不得而知,用于杀灭植物真菌的农药很可能是背后的真实原因。
真菌与人类的相爱相杀
真菌不光可能危害动物健康,同样会危害植物正常生长。
农作物种植过程中,离不开抗真菌药物的使用,土豆、豆类、小麦等作物都需要定期杀灭土壤中的致病真菌。与抗生素的名目繁多不同,抵抗真菌感染的药物种类很少,并且绝大多数都是唑类化合物。而杀灭植物真菌的农药同样含有与唑类化合物类似的结构,这就导致在自然环境中栖息的真菌很可能在农药的作用之下发生耐药性突变,一旦感染人体,与农药结构类似的抗真菌药物也就无法发挥作用了。
其实,人类对耐药真菌的认识达到如今的程度也经历了一个曲折的发展历程。大约在1997年,一种称为烟曲霉菌的常见真菌开始显现耐药性,由耐药烟曲霉菌引发的肺炎死亡率高达60%。起初,医学工作者自然地认为治疗过程中抗真菌药剂的使用是造成真菌菌株发生耐药性变异的原因,治疗中对耐药菌株占总菌株比例的监测事实也似乎证实了这一猜测。
然而,研究过程中却发现不少从未经过唑类化合物治疗的患者体内也发现了耐药性菌株,这说明耐药性菌株在真菌感染患者之初就已经存在了。据此,研究人员开始怀疑环境中本来就已经有耐药菌株的存在,而随后的实验结果佐证了这一猜测。
研究人员在医院周围的花坛、草丛以及空调系统中都发现了耐药菌株的存在,土壤样品中耐药菌株占比高达12%。另外,与医用唑类药物结构类似的抗真菌用脱甲基抑制剂(DMI)类农药在世界农药市场中所占份额高达三分之一,而耐药菌株对DMI类农药也表现出了相应的抵抗能力。
培养皿中的真菌菌落,样品全部来源于土壤
虽然这些观测事实还不足以断定农药应用是真菌耐药性产生的直接原因,但可以断定的是,自然界中已经存在大量的耐药性真菌,并且它们的威力与耳念珠菌不相上下。真菌感染原本以侵袭免疫力低下人群为主,当药物能够正常发挥作用时,感染会很快得到有效抑制。
一旦抗药性真菌出现,“人类武器库”中原本就有限的选择就会捉襟见肘,从而造成易感人群的较高死亡率。
新型抗真菌药将从农药中找灵感
未来,除了进一步探究真菌耐药性、抗菌药物和农药间的关联性,开发抑菌机理迥异的新型抗真菌药同样迫在眉睫。
然而,由于真菌和人类细胞同属真核细胞,两者间存在诸多联系,对真菌细胞有杀灭作用的药物也往往会伤害人体正常细胞,所以人类目前仅能从有限的几个人类与真菌细胞的不同之处出发,来设计抗真菌药物。不幸的是,这些药物中的大部分已经不能有效杀灭耐药菌株。
不过,有不少学者却提出人类其实可以从抗真菌农药中寻找灵感。这是因为除去DMI类药剂,还有若干种农药可以在有效杀灭真菌的情况下保持较低的人体毒性。而这些农药中的相当一部分至今仍处于杀菌机理并未完全解明的状态。从这些行之有效的抗真菌农药中寻找药物设计灵感的思路不失为合理的选择。
食用菌类也属于真菌的一种
事实上,抗药性在抗生素、抗病毒药物、抗真菌药物、抗寄生虫药物乃至抗癌药等各种化学疗法领域都是长久以来存在的问题,是无法回避的宿命。我们要明白人类与微生物的博弈过程将是一场长期而且不断升级的战斗。
在这一过程中,我们既要合理使用抗菌药剂,又要避免因药物不适当应用造成的抗药性。同时,我们还需要将人类与致病微生物所在的整个生态系统都纳入到研究和讨论的范围之内。
参考文献:
1. Mysterious Drug-Resistant Germ Deemed An "Urgent Threat" Is Quietly Sweeping The Globe
2. 真菌感染症分野か?直面している薬剤耐性の现状
3. 真菌の薬剤耐性化の现状は? そして今後は?
4. 感染した人の半分か?「打つ手か?ないまま死亡する」史上最强の耐性真菌カンシ?タ??アウリスか?世界中に拡大。しかも、この真菌は地球て?同时多発的に「突如」现れた奇妙な
5. カンシ?タ??アウリス(Candida auris)感染症
6. 猛毒の真菌、アメリカて?既に6人死亡
医谷链
来源:科学大院
为你推荐
 资讯
资讯 呋喹替尼联合疗法获批晚期肾细胞癌患者二线治疗新适应症
5月21日,和黄医药宣布,其自主研发创新药物呋喹替尼获得中国国家药品监督管理局(NMPA)批准,联合信迪利单抗用于治疗既往接受血管内皮生长因子受体酪氨酸激酶抑制剂(VEGFR-...
2026-05-22 15:56
 资讯
资讯 刚果(金)与乌干达埃博拉疫情:国际SOS发布企业员工支持建议
近日,世界卫生组织(WHO)宣布,当前影响刚果民主共和国和乌干达的埃博拉疫情构成“国际关注的突发公共卫生事件”(PHEIC)。
2026-05-22 13:47
 资讯
资讯 早筛 戒烟 筑牢膀胱癌第一道防线
每年的5月是“膀胱关爱月”,根据国家癌症中心发布的《2024年全国癌症报告》显示,膀胱癌位居我国恶性肿瘤发病第 11 位。2022年中国膀胱癌发病率为7 3 10万人,死亡率为4...
文/刘思 2026-05-22 13:31
 资讯
资讯 再鼎医药总裁兼首席运营官离职
5月22日早间,再鼎医药发布公告称,公司董事会已于5月18日决定,Josh Smiley不再担任公司总裁兼首席运营官,相关决定自当日起生效,其在公司的最后任职日期为5月22日。
2026-05-22 11:45
 资讯
资讯 共建多元支付,加速创新可及:镁信健康与辉瑞中国达成战略合作
双方将依托长期合作基础,以多元支付为基石,以数据洞察和AI技术为引擎,加速前沿创新药落地中国,全方位提升患者用药可及性与健康服务体验,助力构建多层次医疗保障体系。
2026-05-21 17:57
 资讯
资讯 拜耳可申达(非奈利酮片)在中国获批用于LVEF≥40%的心力衰竭成人患者
拜耳宣布中国国家药品监督管理局(NMPA)批准高选择性非甾体类盐皮质激素受体拮抗剂可申达(非奈利酮片)用于射血分数(LVEF)≥40%的心力衰竭成人患者,以降低心血管死亡、因心...
2026-05-21 17:51
 资讯
资讯 冯慧宇教授:从“活下去”到“活得好”,重症肌无力迈入精准治疗时代
作为深耕重症肌无力领域数十年的临床专家,她用一个个真实的患者故事,揭示了这个有着 300 多年历史的古老疾病在当代诊疗中的核心痛点,并分享了对创新药发展和患者全程管理的...
文/张蓉蓉 2026-05-21 15:48
 资讯
资讯 2026年“家庭健康促进计划-健康同行1+1公益项目” 在西安医学院正式启动
5月18日,由中国妇女发展基金会主办,陕西省妇联、陕西妇女儿童发展基金会、西安医学院协办,默沙东公益支持的“家庭健康促进计划-健康同行1+1公益项目西安高校健康跑暨2026启动...
2026-05-21 15:37
 资讯
资讯 爱尔眼科补交税款及滞纳金5.24亿元
5月20日,爱尔眼科(300015 SZ)发布公告称,其根据国家税收法律法规相关要求进行自查后,需补缴税款3 48亿元,并支付滞纳金1 76亿元,合计金额达5 24亿元。目前,上述税款...
2026-05-21 15:36
 资讯
资讯 复宏汉霖引进第三代口服EGFR-TKI产品
近日,复宏汉霖宣布与江苏正大丰海制药有限公司及其旗下江苏创特医药科技有限公司达成战略合作。根据约定,复宏汉霖将获得由江苏创特自主研发的口服小分子三代表皮生长因子受体...
2026-05-21 11:28
 资讯
资讯 冠脉支架国家集采第二轮接续采购在天津开标,27个产品拟中选
5月20日,国家组织冠脉支架集中带量采购第二轮接续采购在天津开标。共15家企业的30个产品参与投标,投标企业全部中选,27个产品获拟中选资格。
2026-05-20 21:05
 资讯
资讯 因美纳发布年度企业责任报告,持续提升基因组学可及性,加速拓展全球影响力
报告重点介绍了公司在推动基因组学公平可及方面取得的持续进展,以及为全球患者、社区和医疗系统带来可衡量的影响
2026-05-20 18:14
 资讯
资讯 罗欣药业因生产劣药被处罚186万元
5月18日,山东省药监局发布的行政处罚信息显示,罗欣药业因生产销售不符合国家药品标准的注射用阿奇霉素,被处以没收药品609支、没收违法所得6 8万元并处罚款180万元,罚没款合...
2026-05-20 16:01
 资讯
资讯 集采心脏支架临床使用超千万
2020年,心脏支架成为首批国家组织高值医用耗材集中带量采购品种,国内外企业的10个临床主流产品中选,普遍降至1000元以下,我国心脏支架基本告别“万元时代”。
2026-05-20 13:46
 资讯
资讯 我国启动首个128通道全植入式脑机接口系统多中心临床试验
5月18日,我国正式启动首个128通道全植入式脑机接口系统多中心临床试验,这项试验由首都医科大学附属北京天坛医院担任组长单位。
2026-05-19 21:08
 资讯
资讯 国产口服小分子GLP-1减重适应症完成III临床试验,即将申报NDA
5月18日,成都闻泰医药科技股份有限公司宣布,公司自主研发的每日一次口服小分子GLP-1受体激动剂VCT220片,在中国超重或肥胖受试者中的关键Ⅲ期临床试验取得积极顶线结果,计划...
2026-05-19 18:07
 资讯
资讯 辐联科技完成超 10 亿人民币融资,加速核药临床开发与全球同位素产能布局
本轮融资由全球医疗健康投资机构维梧资本领投,辐联科技战略合作伙伴 SK Biopharmaceuticals 以及成为资本、红杉中国、佳辰资本、楹联健康基金、Plaisance、Sky9、TSG 资本等多家优质机构跟投。
2026-05-19 18:02